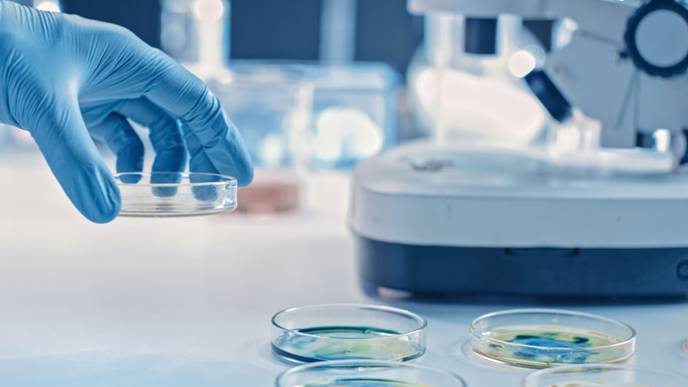
ReachMD Healthcare Image

Discovery of ‘New Rules of the Immune System’ Could Improve Treatment of Inflammatory Diseases, Say Scientists
06/19/2024
This overturns the traditional thinking that regulatory T cells exist as multiple specialist populations that are restricted to specific parts of the body. The finding has implications for the treatment of many different diseases – because almost all diseases and injuries trigger the body’s immune system.
Current anti-inflammatory drugs treat the whole body, rather than just the part needing treatment. The researchers say their findings mean it could be possible to shut down the body’s immune response and repair damage in any specific part of the body, without affecting the rest of it. This means that higher, more targeted doses of drugs could be used to treat disease – potentially with rapid results.
“We’ve uncovered new rules of the immune system. This ‘unified healer army’ can do everything - repair injured muscle, make your fat cells respond better to insulin, regrow hair follicles. To think that we could use it in such an enormous range of diseases is fantastic: it’s got the potential to be used for almost everything,” said Professor Adrian Liston in the University of Cambridge’s Department of Pathology, senior author of the paper.
To reach this discovery, the researchers analysed the regulatory T cells present in 48 different tissues in the bodies of mice. This revealed that the cells are not specialised or static, but move through the body to where they’re needed. The results are published today in the journal Immunity.
“It's difficult to think of a disease, injury or infection that doesn’t involve some kind of immune response, and our finding really changes the way we could control this response,” said Liston.
He added: “Now that we know these regulatory T cells are present everywhere in the body, in principle we can start to make immune suppression and tissue regeneration treatments that are targeted against a single organ – a vast improvement on current treatments that are like hitting the body with a sledgehammer.”
Using a drug they have already designed, the researchers have shown - in mice - that it’s possible to attract regulatory T cells to a specific part of the body, increase their number, and activate them to turn off the immune response and promote healing in just one organ or tissue.
“By boosting the number of regulatory T cells in targeted areas of the body, we can help the body do a better job of repairing itself, or managing immune responses,” said Liston.
He added: “There are so many different diseases where we’d like to shut down an immune response and start a repair response, for example autoimmune diseases like multiple sclerosis, and even many infectious diseases.”
Most symptoms of infections such as COVID are not from the virus itself, but from the body’s immune system attacking the virus. Once the virus is past its peak, regulatory T cells should switch off the body’s immune response, but in some people the process isn’t very efficient and can result in ongoing problems. The new finding means it could be possible to use a drug to shut down the immune response in the patient’s lungs, while letting the immune system in the rest of the body continue to function normally.
In another example, people who receive organ transplants must take immuno-suppressant drugs for the rest of their lives to prevent organ rejection, because the body mounts a severe immune response against the transplanted organ. But this makes them highly vulnerable to infections. The new finding helps the design of new drugs to shut down the body’s immune response against only the transplanted organ but keep the rest of the body working normally, enabling the patient to lead a normal life.
Most white blood cells attack infections in the body by triggering an immune response. In contrast, regulatory T cells act like a ‘unified healer army’ whose purpose is to shut down this immune response once it has done its job - and repair the tissue damage caused by it.
The researchers are now fundraising to set up a spin-out company, with the aim of running clinical trials to test their findings in humans within the next few years.
The research was funded by the European Research Council (ERC), Wellcome, and the Biotechnology and Biological Sciences Research Council (BBSRC).
Reference: Liston, A. ‘The tissue-resident regulatory T cell pool is shaped by transient multi-tissue migration and a conserved residency program.’ Immunity, June 2024. DOI: 10.1016/j.immuni.2024.05.023
